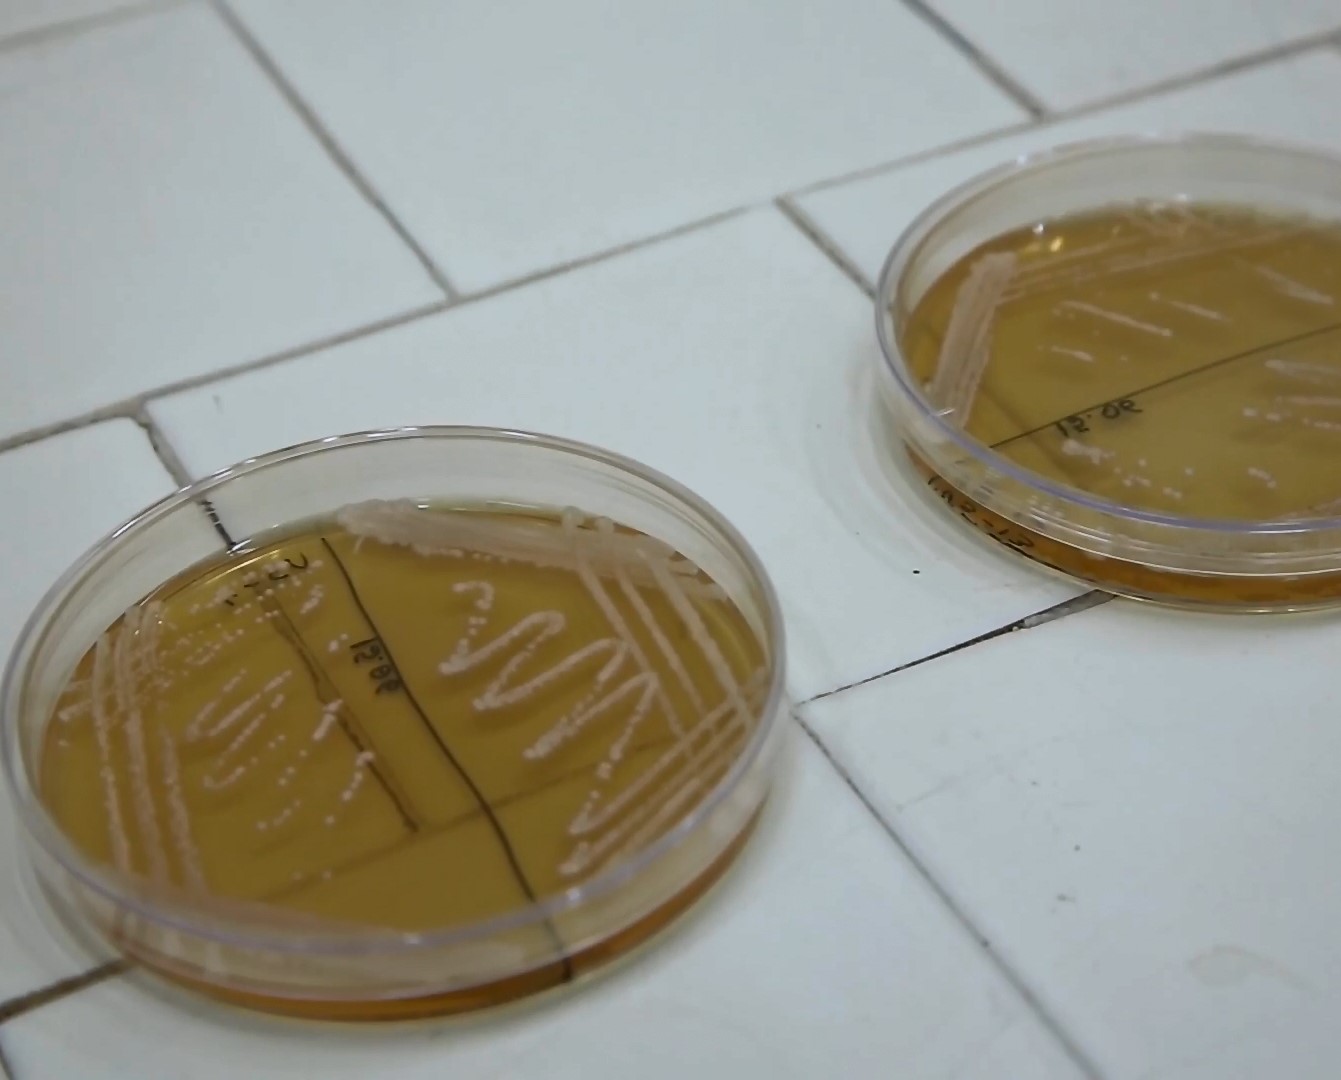
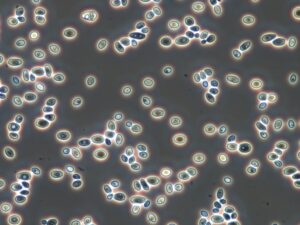
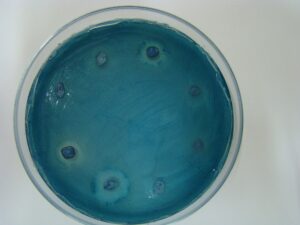

I nostri servizi

Fornitura di lieviti
Presso StarFInn è disponibile un’ampia collezione di lieviti indigeni fermentativi, isolati da diverse matrici alimentari e diverse regioni d’Italia e del mondo, che possono essere distribuiti alle aziende interessate.
Conservazione di lieviti specifici aziendali
Un altro servizio offerto alle aziende la conservazione dei ceppi di lievito, sia quelli specificatamente selezionati dal nostro spin-off che quelli già in uso presso le aziende stesse in modo da garantire alle aziende clienti la disponibilità nel tempo dei propri ceppi, permettendo anche di ripristinare la coltura che sia andata incontro a perdita, contaminazione e instabilità genetica.

Selezione di lieviti specifici
Il team di StarFInn mette a disposizione le proprie competenze per la selezione di lieviti personalizzati, ovvero opportunamente selezionati in funzione delle esigenze aziendali. Il processo di selezione parte dall’isolamento dei lieviti naturalmente presenti nelle matrici da cui si ottiene il prodotto fermentato (ad esempio mosto d’uva o di malto, impasto), che vengono sottoposti ad un processo di caratterizzazione, ovvero un processo composto da diverse fasi, che prevede lo studio sia delle caratteristiche genetiche che dei parametri importanti dal punto di vista tecnologico. Alla fine, si individuano i lieviti potenzialmente più idonei per condurre la fermentazione e che permettono di ottenere un prodotto esclusivo, non imitabile e fatto su misura.
Vieni a scoprire il nostro processo di selezione di lieviti